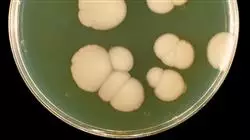
##IMAGE##

Universitäre Qualifikation
Die größte Fakultät für Ernährung der Welt"
Präsentation
Ein einzigartiger akademischer Kurs, der es Ihnen ermöglicht, Ihre Kenntnisse in der Phytotherapie bei gynäkologischen Erkrankungen und Erkrankungen des Harntraktes auf den neuesten Stand zu bringen“

Die Phytotherapie kann aus ernährungswissenschaftlicher Sicht eine wichtige Rolle bei der Behandlung von gynäkologischen und Harnwegserkrankungen spielen.Durch die sorgfältige Auswahl der richtigen Kräuter und Heilpflanzen kann ein therapeutischer Nutzen erzielt und der allgemeine Gesundheitszustand verbessert werden. Im Bereich der gynäkologischen Erkrankungen, wie z. B. der Endometriose, kann die Phytotherapie eine natürliche Alternative zur Linderung der Symptome und zur Förderung des Wohlbefindens bieten. Im Bereich der Harnwege kann der Einsatz von Heilpflanzen bei der Behandlung von Harnwegsinfektionen, Blasenentzündungen, Nierenentzündungen und Harninkontinenz hilfreich sein.
In diesem Zusammenhang ist es wichtig, dass Ernährungsfachkräfte die wirksamsten Techniken der Phytotherapie im Bereich der gynäkologischen und Harnwegserkrankungen kennen. Aus diesem Grund hat TECH einen universitätskurs entwickelt, der Ernährungswissenschaftlern die notwendigen Kenntnisse und Fähigkeiten zur Anwendung dieser Techniken vermittelt. Darüber hinaus werden Konzepte wie Phytotherapie bei Frauen mit prämenstruellem Syndrom und der Einsatz von Phytotherapie zur Behandlung klimakterischer Symptome eingehend untersucht.
In diesem Zusammenhang wird der zu 100% online durchgeführte Studiengang vorgestellt, der den Studenten völlige Zugangsfreiheit bietet, da sie ihn von überall und zu jeder Zeit absolvieren können, indem sie einfach ein internetfähiges Gerät zur Hand haben. Darüber hinaus stellt das Programm den Studenten eine Reihe von Materialien in einer virtuellen Bibliothek zur Verfügung, auf die sie zu jeder Tageszeit und ohne Zeitbeschränkung zugreifen können.
Dank TECH erfahren Sie, wie Sie Phytotherapie bei der Behandlung von Behandlung von Harnwegsinfektionen einsetzen können“
Dieser universitätskurs in Phytotherapie für Gynäkologische und Harnwegserkrankungen enthält das vollständigste und aktuellste wissenschaftliche Programm auf dem Markt. Die wichtigsten Merkmale sind:
- Die Entwicklung praktischer Fälle, die von Experten der Phytotherapie vorgestellt werden
- Der anschauliche, schematische und äußerst praxisnahe Inhalt vermittelt alle für die berufliche Praxis unverzichtbaren wissenschaftlichen und praktischen Informationen
- Praktische Übungen, bei denen der Selbstbewertungsprozess zur Verbesserung des Lernens genutzt werden kann
- Sein besonderer Schwerpunkt liegt auf innovativen Methoden
- Theoretische Vorträge, Fragen an den Experten, Diskussionsforen zu kontroversen Themen und individuelle Reflexionsarbeit
- Die Verfügbarkeit des Intern auf die Inhalte von jedem festen oder tragbaren Gerät mit Internetanschluss
Sie werden Ihr Wissen darüber erweitern, wie die Phytotherapie in Verbindung mit der Ernährung ein wirksames Mittel zur Linderung der Symptome des prämenstruellen Syndroms sein kann“
Zu den Dozenten des Programms gehören Experten aus der Branche, die ihre Erfahrungen in diese Fortbildung einbringen, sowie anerkannte Spezialisten aus führenden Unternehmen und angesehenen Universitäten.
Die multimedialen Inhalte, die mit der neuesten Bildungstechnologie entwickelt wurden, werden der Fachkraft ein situiertes und kontextbezogenes Lernen ermöglichen, d. h. eine simulierte Umgebung, die eine immersive Fortbildung bietet, die auf die Ausführung von realen Situationen ausgerichtet ist.
Das Konzept dieses Programms konzentriert sich auf problemorientiertes Lernen, bei dem die Fachkraft versuchen muss, die verschiedenen Situationen aus der beruflichen Praxis zu lösen, die während des akademischen Kurses auftreten. Zu diesem Zweck wird sie von einem innovativen interaktiven Videosystem unterstützt, das von renommierten Experten entwickelt wurde.
Mit diesem Abschluss sind Sie in der Lage, die wirksamsten Optionen der Phytotherapie bei der Behandlung von Patienten mit benigner Prostatahyperplasie anzuwenden"

Sie lernen die medizinischen Eigenschaften von Pflanzen kennen und erfahren, wie Sie diese in eine gesunde Ernährung zur Vorbeugung und Behandlung von Harnsteinleiden integrieren können"
Ziele und Kompetenzen
Das Ziel dieses Programms ist es, Ernährungsfachleuten die aktuellsten Kenntnisse und Fähigkeiten zu vermitteln, die auf dem Gebiet der Phytotherapie für die Anwendung bei gynäkologischen und Harnwegserkrankungen erforderlich sind. Auf diese Weise erwerben die Fachkräfte spezifische Kenntnisse über Heilpflanzen und ihre gesundheitsfördernden Eigenschaften in diesen Bereichen. Auf dieser Grundlage wird er in der Lage sein, Ernährungspläne und spezifische Empfehlungen zu entwerfen, die den angemessenen Einsatz von Heilpflanzen unter Berücksichtigung der individuellen Bedürfnisse und Bedingungen jedes einzelnen Patienten einschließen.
Während dieses Programms werden Sie die Techniken kennenlernen, die es Ihnen ermöglichen, die Phytotherapie im Bereich der Ernährung zur Behandlung der klimakterischen Symptomatik einzusetzen“
Allgemeine Ziele
- Definieren der therapeutischen Grenzen der Phytotherapie und Identifizierung der Fälle, in denen sie sicher eingesetzt werden kann
- Beschreiben der Anwendung der Phytotherapie zur Befriedigung der Bedürfnisse, die sich aus den Gesundheitsproblemen des Patienten ergeben, und zur Vorbeugung von Komplikationen eine sichere und qualitativ hochwertige Praxis zu gewährleisten
- Lösen von Fällen aus dem Bereich der Phytotherapie
- Erklären der Verwendung und Indikation von Medizinprodukten, Nahrungsergänzungsmitteln und/oder Arzneimitteln, wobei der erwartete Nutzen und die damit verbundenen Risiken zu bewerten sind
- Anwenden theoretischer Kenntnisse in der täglichen Praxis a
Spezifische Ziele
- Beschreiben der phytotherapeutischen Behandlungen und der therapeutischen Grenzen bei Erkrankungen des Harnsystems, insbesondere der BPH
- Kennen der phytotherapeutischen Behandlungen und der therapeutischen Grenzen bei gynäkologischen Zuständen wie der Menopause

Sie werden erfahren, wie die Phytotherapie zusammen mit der richtigen Ernährung ein wirksames Mittel sein kann, um die vaginale Gesundheit auszugleichen und zu verbessern"
Universitätskurs in Phytotherapie für Gynäkologische und Harnwegserkrankungen
Entdecken Sie die faszinierende Welt der Phytotherapie bei gynäkologischen und Harnwegserkrankungen! Tauchen Sie ein in eine virtuelle Wissensreise an der renommierten Fakultät für Ernährung der TECH Technologischen Universität und wecken Sie Ihre Leidenschaft für die ganzheitliche Gesundheit der Frau. Möchten Sie spezielle Techniken der Phytotherapie zur Linderung von gynäkologischen und Harnwegserkrankungen beherrschen? Möchten Sie praktische Fähigkeiten zur Förderung des weiblichen Wohlbefindens durch natürliche Medizin erwerben? Verpassen Sie nicht die Gelegenheit, den 6-wöchigen Online-Universitätskurs in Phytotherapie für Gynäkologische und Harnwegserkrankungen zu besuchen. Dieser Kurs bietet Ihnen die Möglichkeit, bequem von zu Hause aus zu lernen, Ihren Zeitplan an Ihre Bedürfnisse anzupassen und engen Kontakt mit dem Lehrteam und Ihren Mitstudenten zu pflegen. Nach Abschluss dieses spannenden Programms werden Sie in der Lage sein, verschiedene gynäkologische und Harnwegserkrankungen durch den verantwortungsvollen Einsatz von Heilpflanzen zu erkennen und wirksam zu behandeln. Sie erhalten ein von der TECH Technologischen Universität anerkanntes Zertifikat, das Ihre während des Kurses erworbenen Kenntnisse und Fähigkeiten unterstützt, Ihr berufliches Profil stärkt und Ihnen neue Möglichkeiten im Bereich der natürlichen Gesundheit eröffnet.
Schreiben Sie sich noch heute ein und machen Sie sich bereit, Ihre Zukunft zu verändern!
Unser Dozententeam, das sich aus renommierten Phytotherapie-Experten zusammensetzt, wird Sie auf dieser Lernreise begleiten und Ihnen das theoretische und praktische Wissen vermitteln, das Sie brauchen, um ein Experte für gynäkologische und urologische Phytotherapie zu werden. Während des Kurses werden Sie sich mit den wichtigsten Frauenkrankheiten wie dem prämenstruellen Syndrom, wiederkehrenden Harnwegsinfektionen, der Menopause und vielen anderen häufigen Beschwerden beschäftigen. Sie werden lernen, wie man bestimmte Heilpflanzen verwendet, die Wirkmechanismen von Phytoöstrogenen verstehen und sich mit den neuesten wissenschaftlichen Forschungen auf dem Gebiet der Phytotherapie für die Gesundheit von Frauen befassen. Ein Studium an der TECH Technologischen Universität bietet Ihnen eine einzigartige Gelegenheit, sich beruflich weiterzuentwickeln und Ihren Horizont in der Welt der natürlichen Gesundheit zu erweitern.







